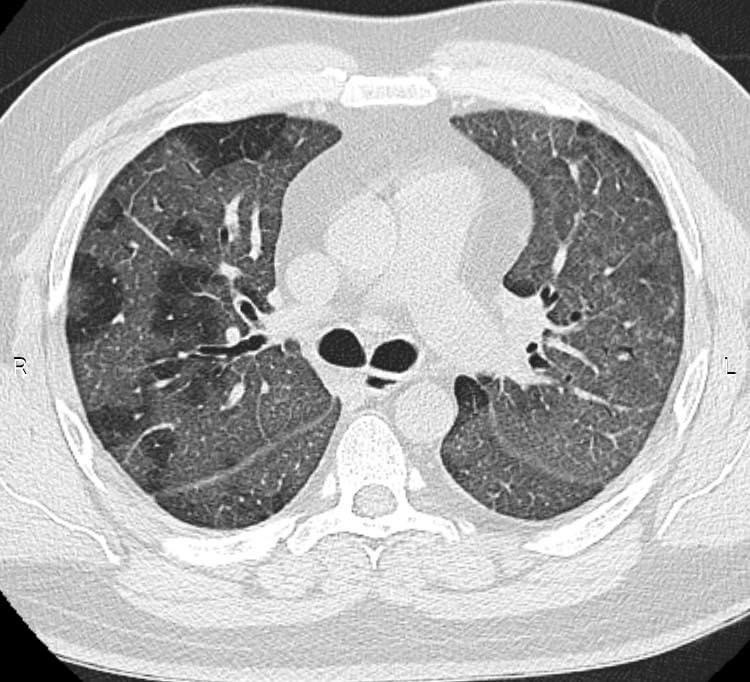

Vereadora quer mais profissionais para a Saúde

A vereadora Presidente do Legislativo gramadense, Rosi Ecker Schimitt, está requerendo informação quanto à questão relativa ao combate do COVID – 19, em Gramado. Ela solicita informações à Prefeitura quanto à previsão da contratação de mais profissionais para saúde no combate ao COVID-19. “A atuação desses profissionais é fundamental nesse momento. Verificamos o aumento de casos na cidade, desta […]
ESF Jardim tem reformas concluídas

A Unidade de Estratégia de Saúde da Família do bairro Jardim está com sua reforma concluída. A obra de remodelação havia iniciado no final do mês de setembro de 2019. No local, diversas melhorias foram realizadas na estrutura, rede elétrica, rede sanitária e hidráulica, além do acabamento e estética. Conforme a Secretaria Municipal de Governança […]
Médico Fabiano Ruoso está vencendo a Covid-19
Vítima do Covid-19, o médico Fabiano Ruoso segue internado no Hospital Moinhos de Vento em Porto Alegre onde fez tratamento intensivo. Fabiano está prestes a deixar a CTI daquele complexo hospitalar e ir para um quarto para a recuperação final. Ele postou em sua rede social toda sua luta para vencer o Covid. Ele conta […]
Canela tem 11 novos casos e 13 pacientes recuperados
Em boletim divulgado na tarde desta terça-feira (11), 11 novos testes resultaram positivo para Covid-19. Com isso, o município chega a marca de 353 confirmados desde o início da pandemia. Além disso, 13 pacientes foram liberados, sendo considerados recuperados da doença. Já são 307 pessoas recuperadas. Assim como nos últimos dias, o número de casos […]
Obras no VITA Boulevard estão dentro do prazo

As obras do VITA Boulevard em Gramado estão dentro do prazo e o empreendimento será entregue na data prevista, em dezembro de 2020. Em abril o VITA retomou as atividades de forma gradativa no canteiro de obras seguindo todos os protocolos de higiene e segurança e atendendo rigidamente ao Decreto Municipal 081/2020 da Prefeitura de Gramado. Atualmente dispõe de […]
Pavimentação no Morro Agudo tem 80% das obras concluídas

A pavimentação no Morro Agudo já está com 80% das obras concluídas. O prefeito de Gramado, Fedoca Bertolucci, esteve na localidade no final da semana passada para acompanhar os trabalhos. A previsão de término das obras é para o final do mês de agosto e compreende cerca de 2,34 km de trecho revestidos. O prazo […]
Festival de Cinema de Gramado anuncia homenagens e Curtas Brasileiros selecionados

Já em contagem regressiva para a realização do formato multiplataforma do Festival de Cinema de Gramado, que será transmitido pela TV, no Canal Brasil, e por streaming, a organização divulga mais uma importante etapa da 48ª edição: os curtas-metragens brasileiros (CMB) selecionados e os nomes do homenageados com o Troféu Oscarito e Troféu Eduardo Abelin. Este ano, serão 14 títulos […]
Grupo Dial emite Nota Oficial, confirma que a pandemia afetou os negócios da Rádio em Gramado, e anuncia novo projeto

O Grupo Dial, que administra a Rádio Sorriso de Gramado, envia Nota Oficial falando do nosso post em primeira mão sobre o fechamento da Sorriso Serra. Confira na íntegra o que disse a empresa: O Grupo Dial de Comunicação gostaria da oportunidade de esclarecer os rumores publicados no dia 10 de agosto sobre o fechamento […]
Covid-19: registrado 9º óbito de residente em Gramado

O Centro de Operações em Emergências – COE Gramado e o Hospital São Miguel lamentam o registro de óbito de moradora de Gramado, com diagnóstico positivo para Covid-19. Ela tinha 60 anos e faleceu às 19h30 desta segunda-feira, dia 10. É nono óbito de residente do município.
Crise econômica faz a Rádio Sorriso encerrar atividades em Gramado

A Rádio Sorriso de Gramado vai encerrar atividades. A atual crise econômica que afetou muitas empresas não foi diferente com a Rádio que chegava a abranger mais de 50 municípios. O comunicado oficial pegou toda equipe de Gramado de surpresa no início da tarde desta segunda-feira, dia 10. “Estávamos com dificuldades para faturar, é o […]
